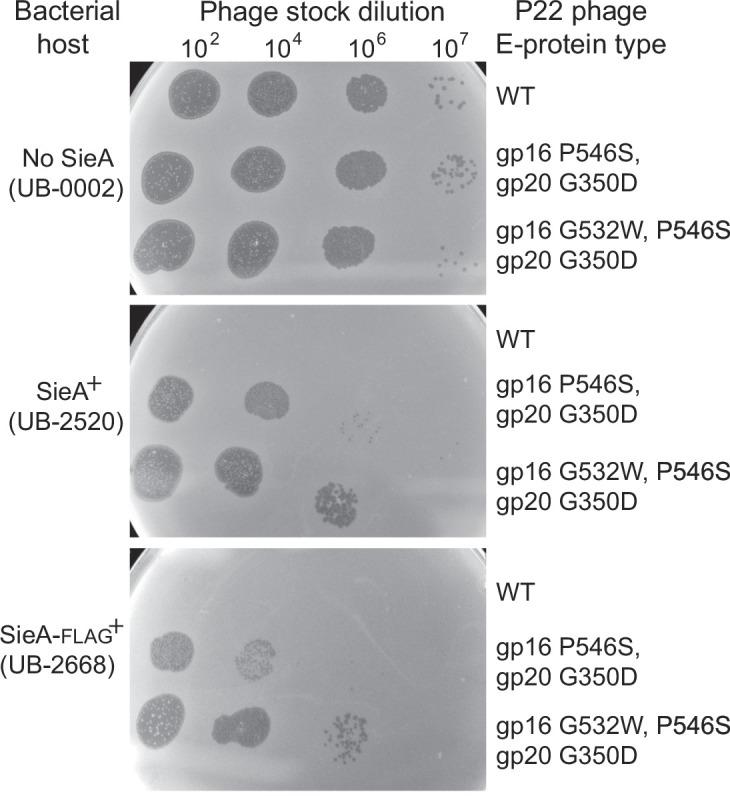
https://cdn.ncbi.nlm.nih.gov/pmc/blobs/dded/10883804/a45cca2c1100/mbio.02169-23.f001.jpg

噬菌体 P22 SieA 介导的超级感染排斥。
Bacteriophage P22 SieA-mediated superinfection exclusion.
机构信息
School of Biological Sciences, University of Utah, Salt Lake City, Utah, USA.
Department of Molecular and Cell Biology, University of Connecticut, Storrs, Connecticut, USA.
出版信息
mBio. 2024 Feb 14;15(2):e0216923. doi: 10.1128/mbio.02169-23. Epub 2024 Jan 18.
Many temperate phages encode prophage-expressed functions that interfere with superinfection of the host bacterium by external phages. phage P22 has four such systems that are expressed from the prophage in a lysogen that are encoded by the (repressor), , , and genes. Here we report that the P22-encoded SieA protein is necessary and sufficient for exclusion by the SieA system and that it is an inner membrane protein that blocks DNA injection by P22 and its relatives, but has no effect on infection by other tailed phage types. The P22 virion injects its DNA through the host cell membranes and periplasm via a conduit assembled from three "ejection proteins" after their release from the virion. Phage P22 mutants that overcome the SieA block were isolated, and they have amino acid changes in the C-terminal regions of the gene and encoded ejection proteins. Three different single-amino acid changes in these proteins are required to obtain nearly full resistance to SieA. Hybrid P22 phages that have phage HK620 ejection protein genes are also partially resistant to SieA. There are three sequence types of extant phage-encoded SieA proteins that are less than 30% identical to one another, yet comparison of two of these types found no differences in phage target specificity. Our data strongly suggest a model in which the inner membrane protein SieA interferes with the assembly or function of the periplasmic gp20 and membrane-bound gp16 DNA delivery conduit.IMPORTANCEThe ongoing evolutionary battle between bacteria and the viruses that infect them is a critical feature of bacterial ecology on Earth. Viruses can kill bacteria by infecting them. However, when their chromosomes are integrated into a bacterial genome as a prophage, viruses can also protect the host bacterium by expressing genes whose products defend against infection by other viruses. This defense property is called "superinfection exclusion." A significant fraction of bacteria harbor prophages that encode such protective systems, and there are many different molecular strategies by which superinfection exclusion is mediated. This report is the first to describe the mechanism by which bacteriophage P22 SieA superinfection exclusion protein protects its host bacterium from infection by other P22-like phages. The P22 prophage-encoded inner membrane SieA protein prevents infection by blocking transport of superinfecting phage DNA across the inner membrane during injection.
许多温和噬菌体编码了噬菌体表达的功能,这些功能干扰了宿主细菌被外部噬菌体的再次感染。噬菌体 P22 有四个这样的系统,这些系统由噬菌体 P22 的 prophage 表达,由 (阻遏物)、 、 、 和 基因编码。在这里,我们报告说,P22 编码的 SieA 蛋白是排除 SieA 系统所必需和充分的,它是一种内膜蛋白,阻止 P22 和其亲缘噬菌体的 DNA 注入,但对其他有尾噬菌体类型的感染没有影响。P22 病毒粒子通过宿主细胞膜和周质通过从病毒粒子中释放出来的三个“喷射蛋白”组装的导管将其 DNA 注入。克服了 SieA 阻断的 P22 突变体被分离出来,它们在编码喷射蛋白的基因 和 编码的 C 末端区域有氨基酸变化。这些蛋白中的三个不同的单一氨基酸变化足以获得对 SieA 的几乎完全抗性。具有噬菌体 HK620 喷射蛋白基因的杂交 P22 噬菌体也对 SieA 有部分抗性。现有的噬菌体编码的 SieA 蛋白有三种序列类型,彼此之间的相似度不到 30%,然而对其中两种类型的比较没有发现噬菌体靶标特异性的差异。我们的数据强烈表明,内膜蛋白 SieA 干扰了周质中的 gp20 和膜结合的 gp16 DNA 输送导管的组装或功能。
重要的是,细菌和感染它们的病毒之间正在进行的进化斗争是地球细菌生态学的一个关键特征。病毒可以通过感染它们来杀死细菌。然而,当它们的染色体作为原噬菌体整合到细菌基因组中时,病毒也可以通过表达保护宿主细菌免受其他病毒感染的产物来保护宿主细菌。这种防御特性称为“超级感染排除”。很大一部分细菌都携带编码这种保护系统的原噬菌体,并且有许多不同的分子策略来介导超级感染排除。本报告首次描述了噬菌体 P22 SieA 超级感染排除蛋白保护其宿主细菌免受其他 P22 样噬菌体感染的机制。P22 原噬菌体编码的内膜 SieA 蛋白通过阻止超感染噬菌体 DNA 在注射过程中穿过内膜运输来阻止感染。